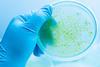

Energy, fuels and sustainable energy – Page 9
-

-
 Research
ResearchCooking up sustainable battery materials in the microwave
Improved sodium-ion battery anodes synthesised while avoiding conventional solvents
-
 Opinion
OpinionReverse combustion is preparing for takeoff
Where burning hydrocarbons is unavoidable, creating them from atmospheric carbon is a promising option
-
 News
NewsBiogas reactor offers a route to decentralising ‘green’ hydrogen production
Chemical looping process produces ultra-pure hydrogen from methane
-
 Business
BusinessOil & Gas industry emissions reduction pledges under scrutiny
Under increasing pressure, big firms are making sweeping climate pledges. How do they stack up?
-
 Research
ResearchJet fuel from sunlight and air could decarbonise the aviation industry
Larger versions of rooftop refinery could satisfy global demand for kerosene – if the sector commits to technological changes
-
 Feature
FeatureHow ammonia could decarbonise shipping
Andy Extance discovers why the compound best known as a fertiliser is a surprising candidate to power enormous container ships
-
 Research
ResearchBurning metal to make clean energy
An unlikely sounding technology that is greener than you might think
-
 News
NewsBioenergy emissions scrutinised as UK plans to grow sector
Questions raised on carbon neutrality vs climate neutrality
-
 Feature
FeatureThe RSC’s climate challenge
The Royal Society of Chemistry aims to use Cop26 as a springboard to a more sustainable future. Rachel Brazil reports
-
 News
NewsNet zero strategy sets sights on slashing UK industry’s emissions by 2035
Carbon capture and storage, nuclear and hydrogen will all play a part in making industry greener
-
 Research
ResearchMaterials swap cuts cost of green hydrogen device
Coating allows titanium electrolyser components to be replaced with stainless steel
-
 Research
ResearchElectrochemistry reduces waste burden of irradiated nuclear graphite
Radioactive contaminants removed from moderator material using electrolysis in high-temperature molten salt media
-
 Webinar
WebinarOptimising battery performance through materials characterisation
Discover how materials understanding is key to optimising the performance of battery technology and explore several key technologies to perform this characterisation
-
 Research
ResearchSystem combines salt and sunlight for off-grid cooling
Dissolution cooling and solute regeneration work together in renewable-energy driven process
-
Research
ResearchCyanobacteria engineered to accept external electricity turn carbon dioxide into fuel
Replacing photosystem II with an exogenous supply of electrons overcomes limitations of natural photosynthesis to fix carbon dioxide more efficiently
-
 Business
BusinessIndia pushes renewables and green hydrogen
Prime minister Modi wants country to be energy independent by 2047 and become a global hydrogen hub
-
 Research
ResearchFlip battery sideways for NMR studies
By turning button batteries on their side they can be studied by nuclear magnetic resonance without removing their metal casing
-
 News
NewsTrial of hydrogen to heat UK homes and university hailed a success
Safety and practicality of blending 20% hydrogen with methane confirmed in pilot project
-
 Research
ResearchChemical definition of brine as water could help clear up Chile’s lithium controversy
As evidence grows that lithium mining damages water sources, reclassifying brine as water – rather than as mineral – could empower Indigenous communities to protect their rights and convince mining companies to act more responsibly